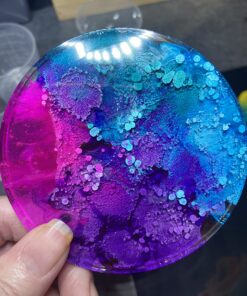
Jacquard Alcohol Ink Set - Pinata Color Exciter Pack - Highly Saturated - Acid-Free - 9 Assorted Colors Half Ounce 66 81j 2BVb sL

Jacquard Alcohol Ink Set – Pinata Color Exciter Pack – Highly Saturated – Acid-Free – 9 Assorted Colors Half Ounce
Description
Pinata Colors are highly-saturated, fast-drying alcohol inks for any surface,
including glass, metal, plastic, ceramic, stone, leather, epoxy resin, polymer
clay, YUPO and more. Indelible and impervious to water, Pinata Colors clean up
with alcohol and re-wet themselves, allowing for unique effects and techniques
not easily achieved with water-based inks. Only the most lightfast dyes have
been selected for the palette, and special formulary technology allows more
color into each bottle. Possibly most impressive is the Pinata Colors opens up
for non-porous surfaces. By easily re-wetting with alcohol, blowing the color
across the surface with air, moving the surface by hand, pouring, or applying
with a paint brush, you can achieve incredible effects. Acid-free and with
excellent adhesive properties, Pinata colors are the go-to inks. Conforms to
ASTM D4236. Made in the USA.
Features:
- Highly-Saturated & Fast-Drying Blendable Inks: A small amount goes a long way. Super Concentrated with Unparalleled Vibrancy, Jacquard Pinata Colors are the brightest, most vivid alcohol ink colors available!
- Extremely Versatile: Use on any clean surface, including yupo paper, epoxy resin, glass, ceramic, metal, polymer clay, leather and more. Permanent and durable.
- Indelible & Impervious to Water: The quality of the colors will not be affected on surfaces that may get wet; theyll look as good as when first applied. Special effects and cleanup are easy with Rubbing Alcohol or Jacquard Clean Up Solution.
- Made in the USA: Unique formula technology allows Jacquard to pack more color into every bottle. Jacquard is a pioneer of alcohol inks and Pinata remains the most esteemed brand in alcohol inks today!
- Colors Included in this Exciter Pack: Rich Goldthe most reflective metallic ink in the world; Blanco Blancohighly pigmented dense white ink, essential for color blending and petri resin art; Seven essential alcohol ink colorsSunbright Yellow, Calabaza Orange, Senorita Magenta, Passion Purple, Baja Blue, Rainforest Green, and Mantilla Black. 9-1/2 ounce bottles.
Product Details:
- Brand: Jacquard
- Ink Color: Assorted Colors
- Package Information: Bottle
- Paint Type: Alcohol
- Item Volume: 14.79 Milliliters
- Product Dimensions: 11 x 1.2 x 8.4 inches
- Item model number: JAC9916
- Is Discontinued By Manufacturer: No
- Item Weight: 8.6 ounces
- Manufacturer: JACQUARD PRODUCTS
- Date First Available: November 8, 2004

Safety 1st Sleepy Baby Nail Clipper (Colors May Vary) 1 Pack Colors May Vary
Honda 72560-VH8-642AH Semi-Matic Trimmer Head
Flip Travel Charger for Nintendo DS Lite
Metroid: Samus Returns - Nintendo 3DS Standard Disc
Brybelly Two Deck Automatic Card Shuffler - Battery-Operated Electric Shuffler - Great for Home & Tournament Use for Classic Poker & Trading Card Games
3M AquaPure AP431 Scale Inhibition Replacement Cartridge, Easy Change High Capacity Water Filter for AP430SS Replacement Water Filter
Adams Job Work Order Book, 5.56 x 8.44 Inch, 3-Part, Carbonless, 33 Sets, White and Canary (T5868)
Destiny: The Taken King - Legendary Edition - Xbox 360
Redragon M901 Gaming Mouse Wired, [Programmable] MMO RGB LED Mice, 24000 DPI, Optical High Precision Sensor, Weight Tuning Set, 18 Buttons for Windows PC Games - Black
Green vege Bento 3 Compartment Meal Prep Food Storage Reusable Lunch Containers,10 Pack,Black
Legendary Link Master Sword of Time - Real Carbon Steel Version
SZCO Supplies Brass Crusader Helmet
5 Pack Easy@Home 6 Panel Instant Drug Test Kits - Testing Marijuana (THC), Amphetamine(AMP), Benzodiazepines(BZO), Cocaine(COC), Opiates(OPI 2000), Methamphetamine(MET/mAMP)-#EDOAP-264 5 Pack
Last Samurai Japanese Sword Katana Honor w/Free Stand (Original Version) Original Version
31" Gladius Roman Sword Gladiator Julius Caesar
Razer Goliathus Medium CONTROL Soft Gaming Mouse Mat - Mouse Pad of Professional Gamers
Aiskaer 4pcs Wii/Gamecube Controller Extension Cables for GameCube and Wii Consoles
Glory Closed Hole C Flute With Case, Tuning Rod and Cloth,Joint Grease and Gloves Nickel Siver-More Colors available,Click to see more colors
Rockin' Green Natural Laundry Detergent Powder | Classic Rock, Lavender Mint | HE, 90 Loads - 45oz Perfect for Cloth Diapers Lavender Mint Revival Standard Packaging
Final Fantasy XIV: Stormblood - PlayStation 4 Standard Edition Disc
A Plague Tale: Innocence (PS4) - PlayStation 4 Disc
Kingdoms of Amalur: Reckoning - Playstation 3 Standard Box
Good Burger (1997) DVD
September 24, 2013
Turtle Beach - Ear Force XO One Amplified Gaming Headset and Headset Audio Controller- Xbox One New
Moleskine Classic Notebook, Hard Cover, Large (5" x 8.25") Ruled/Lined, White
Microsoft Flight Simulator X Standard DVD - PC
Zacro PS4 Vertical Stand Cooling Fan Dual Charging Station for Playstation 4 Dual Shock 4 Controllers, with Dual USB HUB Charger Ports -Dual Use with Cooling and Charging System(Not for PS4 Slim/Pro)